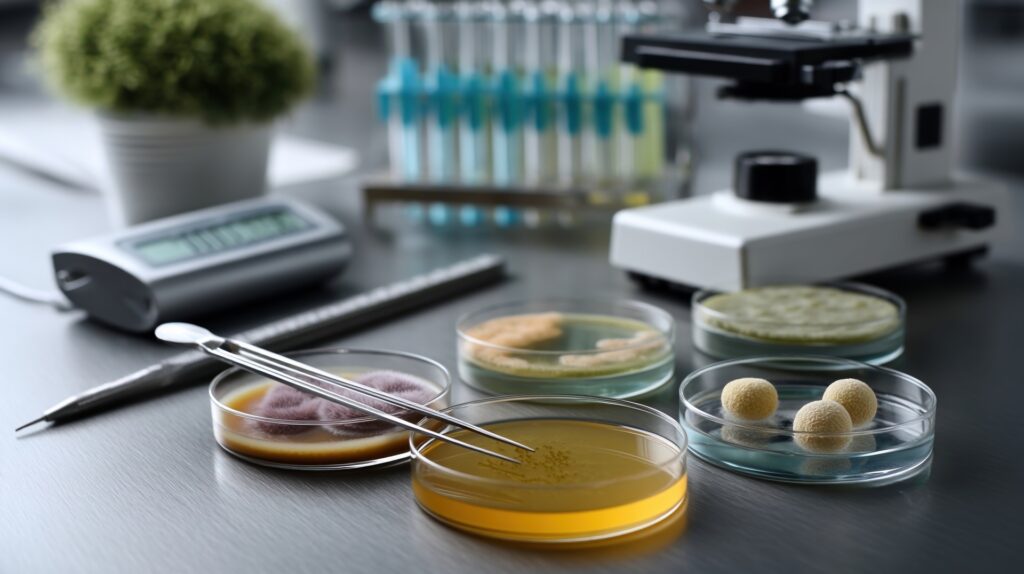

Clinically Researched Postbiotic: Lactococcus lactis Strain Plasma (LC-Plasma) and Its Benefits for Immunity, Work Performance, and Skin Health
Lactococcus lactis strain Plasma (LC-Plasma) is a clinically researched postbiotic that has garnered widespread attention for its remarkable ability to enhance immunity, improve work performance, and promote skin health. This unique strain has been shown to activate plasmacytoid dendritic cells (pDCs), which serve as critical immune system regulators. These cells play a pivotal role in coordinating immune responses by stimulating B, T, and natural killer (NK) cells, all of which are essential components of the body’s defense mechanisms. Notably, pDCs are vital for antiviral defense, primarily through their production of type I and III interferons, which are crucial for combating viral infections effectively [1].
A key feature of LC-Plasma is that its immune-activating properties are driven by its DNA, meaning both live and heat-killed forms of the strain deliver identical beneficial effects. This versatility makes LC-Plasma an ideal candidate for incorporation into a wide range of functional foods, beverages, and dietary supplements without compromising efficacy [2]. Clinical studies conducted on healthy individuals have demonstrated that consuming either form of LC-Plasma significantly enhances pDC activity, resulting in a more robust immune response. For instance, a daily dose of 100 billion cells has been associated with a noticeable reduction in cold-like symptoms, helping individuals maintain their health during seasonal challenges. Additionally, this dosage has been linked to decreased fatigue following intense physical activity, making it a valuable supplement for athletes, fitness enthusiasts, or anyone with a demanding lifestyle [3].
In a separate study involving healthy office workers, four weeks of LC-Plasma intake significantly improved work performance by lowering the risk of infections. This reduction in infection risk translates to fewer sick days, enhanced productivity, and improved overall well-being, which is particularly beneficial in high-pressure work environments where maintaining focus and energy is essential [4]. The ability of LC-Plasma to support immune resilience empowers individuals to perform at their best, even during periods of stress or increased exposure to pathogens, making it a practical solution for modern, fast-paced lifestyles.
Beyond its immune-boosting effects, LC-Plasma has shown promising benefits for skin health. Research suggests that oral intake of heat-killed LC-Plasma may protect against skin infections by enhancing the skin’s immune defenses, likely due to its systemic modulation of immune responses that extend to the skin [5]. Furthermore, LC-Plasma supports the skin microbiome—the diverse community of microorganisms residing on the skin’s surface—by promoting a balanced microbial environment. This balance is essential for maintaining healthy skin and preventing acne, dermatitis, or other irritations. Additionally, LC-Plasma has been found to influence genes involved in skin homeostasis, which refers to the skin’s ability to maintain its natural balance and barrier function. By supporting these genetic processes, LC-Plasma contributes to overall skin health and resilience [5].
The multifaceted benefits of LC-Plasma position it as a standout postbiotic for individuals seeking to optimize their immune health, work performance, and skin vitality. Its ability to function effectively in both live and heat-killed forms opens up exciting possibilities for its use in innovative products, such as probiotic drinks, capsules, or even fortified foods like yogurt or snacks. As consumer interest in preventive health and wellness grows, LC-Plasma offers a scientifically backed option for those looking to incorporate cutting-edge postbiotics into their daily routines. Ongoing research is exploring additional applications, such as its potential role in supporting gut health, reducing stress-related immune suppression, and even enhancing mental clarity through the gut-skin-immune axis. These emerging areas of study highlight the broader implications of LC-Plasma in the evolving field of postbiotics, making it a promising ingredient for the future of functional nutrition. For more detailed insights, refer to the following studies:
References:
- https://pmc.ncbi.nlm.nih.gov/articles/PMC8000884/
- https://pmc.ncbi.nlm.nih.gov/articles/PMC8539941/
- https://pmc.ncbi.nlm.nih.gov/articles/PMC9475960/
- https://pmc.ncbi.nlm.nih.gov/articles/PMC7333011/
- https://pmc.ncbi.nlm.nih.gov/articles/PMC10096552/